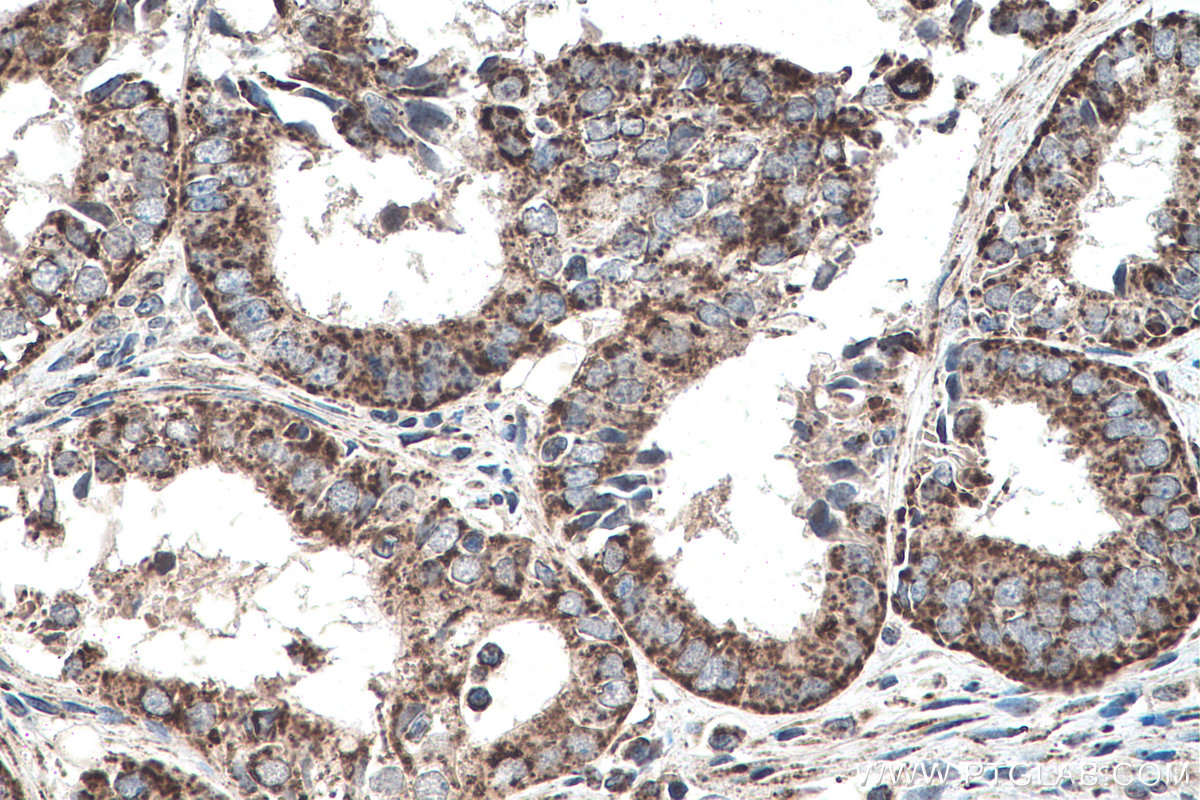

验证数据展示
经过测试的应用
| Positive WB detected in | HeLa cells, rat kidney tissue, HepG2 cells, LNCaP cells, PC-3 cells, mouse liver tissue, rat liver tissue |
| Positive IP detected in | mouse liver tissue |
| Positive IHC detected in | human liver cancer tissue, mouse kidney tissue, human pancreas cancer tissue, human ovary tumor tissue, mouse embryo tissue Note: suggested antigen retrieval with TE buffer pH 9.0; (*) Alternatively, antigen retrieval may be performed with citrate buffer pH 6.0 |
| Positive IF detected in | mouse kidney tissue |
| Positive FC (Intra) detected in | HepG2 cells |
推荐稀释比
| 应用 | 推荐稀释比 |
|---|---|
| Western Blot (WB) | WB : 1:500-1:3000 |
| Immunoprecipitation (IP) | IP : 0.5-4.0 ug for 1.0-3.0 mg of total protein lysate |
| Immunohistochemistry (IHC) | IHC : 1:50-1:500 |
| Immunofluorescence (IF) | IF : 1:10-1:100 |
| Flow Cytometry (FC) (INTRA) | FC (INTRA) : 0.40 ug per 10^6 cells in a 100 µl suspension |
| It is recommended that this reagent should be titrated in each testing system to obtain optimal results. | |
| Sample-dependent, Check data in validation data gallery. | |
产品信息
20697-1-AP targets SHH in WB, IHC, IF, FC (Intra), IP, ELISA applications and shows reactivity with human, mouse, rat samples.
| 经测试应用 | WB, IHC, IF, FC (Intra), IP, ELISA Application Description |
| 文献引用应用 | WB, IHC, IF |
| 经测试反应性 | human, mouse, rat |
| 文献引用反应性 | human, mouse, rat, mink |
| 免疫原 |
Peptide 种属同源性预测 |
| 宿主/亚型 | Rabbit / IgG |
| 抗体类别 | Polyclonal |
| 产品类型 | Antibody |
| 全称 | sonic hedgehog homolog (Drosophila) |
| 别名 | EC:3.1.-.-, HHG 1, HHG1, HHG-1, HLP3 |
| 计算分子量 | 50 kDa |
| 观测分子量 | 45-51 kDa |
| GenBank蛋白编号 | NM_000193 |
| 基因名称 | SHH |
| Gene ID (NCBI) | 6469 |
| RRID | AB_10694828 |
| 偶联类型 | Unconjugated |
| 形式 | Liquid |
| 纯化方式 | Antigen affinity purification |
| UNIPROT ID | Q15465 |
| 储存缓冲液 | PBS with 0.02% sodium azide and 50% glycerol, pH 7.3. |
| 储存条件 | Store at -20°C. Stable for one year after shipment. Aliquoting is unnecessary for -20oC storage. |
背景介绍
Sonic hedgehog (SHH) is a member of the Hedgehog (Hh) family of proteins that control cell growth, survival,
and fate.
What is the molecular weight of SHH?
The molecular weight of SHH is approximately 45 kDa, but it is cleaved autocatalytically to generate a 20 kDa
N-terminal fragment and a 25 kDa C-terminal fragment responsible for hedgehog biological activity and the
auto-processing machinery respectively (PMID: 10753901).
What is the tissue specificity of SHH?
SHH is the most broadly expressed mammalian Hh signaling molecule. During early vertebrate development,
SHH is expressed in midline tissues such as the node, notochord, and floor plate to control the left-right and
dorso-ventral patterning of the embryo (PMID: 12729563). SHH is expressed in fetal intestine, liver, kidney,
and lung tissue, but is not expressed in adult tissues.
What is the cellular localization of SHH?
SHH is localized to the cell membrane. The N-terminal fragment is associated with lipid rafts at the cell surface,
whereas the C-terminal fragment diffuses from the cell.
What is the role of SHH in the Sonic hedgehog signaling pathway?
This pathway is one of the major trafficking networks that regulate key events during developmental growth
and patterning (PMID: 19368798). Loss of SHH signaling and regulation has been implicated in birth defects,
tissue regeneration, stem cell renewal, and cancer growth (PMID: 15549094). The regulatory action of the SHH
pathway is linked to the secretion, uptake, and translocation of the SHH protein; a ligand precursor, which is
implicated in the regulation of the central nervous system polarity and neural patterning (PMID: 11130178,
11801325).
实验方案
| Product Specific Protocols | |
|---|---|
| IHC protocol for SHH antibody 20697-1-AP | Download protocol |
| IP protocol for SHH antibody 20697-1-AP | Download protocol |
| WB protocol for SHH antibody 20697-1-AP | Download protocol |
| Standard Protocols | |
|---|---|
| Click here to view our Standard Protocols |
发表文章
| Species | Application | Title |
|---|---|---|
Sci Bull (Beijing) Restoring sweat gland function in mice using regenerative sweat gland cells derived from chemically reprogrammed human epidermal keratinocytes | ||
Small Odontogenesis-Empowered Extracellular Vesicles Safeguard Donor-Recipient Stem Cell Interplay to Support Tooth Regeneration | ||
Nat Commun TSPAN8 promotes cancer cell stemness via activation of sonic Hedgehog signaling. | ||
J Nanobiotechnology NaHS@Cy5@MS@SP nanoparticles improve rheumatoid arthritis by inactivating the Hedgehog signaling pathway through sustained and targeted release of H2S into the synovium | ||
Cell Rep Multicilia dynamically transduce Sonic Hedgehog signaling to regulate choroid plexus functions | ||
Theranostics Single-cell Transcriptome Profiling reveals Dermal and Epithelial cell fate decisions during Embryonic Hair Follicle Development. |